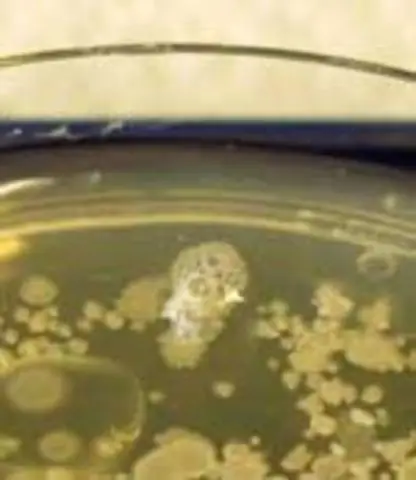
Какие бактерии являются каталазо-положительными и оксидазно-отрицательными?

Этиология. Грамм - положительный кокки включают стафилококки ( каталаза - положительный ), на котором растет гроздь и стрептококк ( каталаза - отрицательный ), который растет цепочками. Стафилококки подразделяются на коагулазо положительный (S. aureus) и коагулаза- отрицательный (С.
Какие бактерии являются каталазоположительными?
Стафилококки и микрококки каталаза - положительный. Другой каталаза - положительный Организмы включают Listeria, Corynebacterium diphtheriae, Burkholderia cepacia, Nocardia, семейство Enterobacteriaceae (Citrobacter, E.
Аналогичным образом, какие бактерии являются отрицательными по оксидазе? Бактерии рода, охарактеризованные как положительные по оксидазе, включают: Neisseria и Pseudomonas и т. д. Роды семейства Enterobacteriaceae характеризуются как оксидаза-отрицательные.
Точно так же спрашивают, какие бактерии являются оксидазно-положительными?
Положительные на оксидазу организмы: Псевдомонады, Neisseria, Алкалигены, Aeromonas, Campylobacter, Vibrio, Brucella, Pasteurella, Moraxella, Helicobacter pylori, Legionella pneumophila и т. Д.
Все ли грамотрицательные бактерии на каталазу положительны?
Использование Каталазный тест Результаты каталазный тест в основном используется для различения Грамм - положительный кокки: представители рода Staphylococcus каталаза - положительный, а представители родов Streptococcus и Enterococcus каталаза - отрицательный.